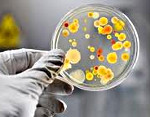

Дизентерия у детей как проявляется чем лечить профилактика
Осторожно — дизентирия
Из многочисленных инфекционных заболеваний особое место занимает дизентерия. Ею болеют люди практически во всех странах мира независимо от социального положения, национальности, расовой принадлежности, пола и возраста. Но особенно часто болеют дети в возрасте 3-6 лет. Заболевание регистрируется повсеместно в течение всего года, но наиболее благоприятный для дизентерии период — летне-осенний.
Что такое дизентерия?

Это инфекционное заболевание, характеризующееся поражением преимущественно толстого кишечника, сопровождающееся поносом с примесью слизи и крови и выраженными явлениями общей интоксикации организма больного.
Возбудителями дезентерии являются бактерии, объединенные общим названием «шигеллы», по имени японского ученого Шига, доказавшего их роль в возникновении болезни. Но в последние годы обнаружены различные формы дизентерии, обусловленные видом возбудителя — Григорьева-Шига, Зонне и Флекснера.
Бактерии длительно сохраняются в пищевых продуктах (молоко, масло, сыр, овощи); выживают в почве, загрязненной испражнениями больных до 3-5 месяцев, в выгребных ямах, открытых водоемах до 50 суток, в водопроводной воде — до 1 месяца.
Источники и пути передачи инфекции
Источниками возбудителя дизентерии являются:
- больной человек;
- бактерионоситель, у которого клиника заболевания отсутствует.
Пути передачи:
Бытовой — заражение происходит при непосредственном соприкосновении с больным (например, при уходе за ним), через загрязненные руки больного (или бактерионосителя), предметы обихода: посуду, дверные ручки, выключатели и т.п.

- Пищевой — с загрязненных рук больного возбудитель дизентерии попадает на пищевые продукты либо на посуду для пищи (воды). В теплое время года (особенно летом и осенью) пищевые продукты загрязняются мухами, переносящими частицы кала, содержащие бактерии. Употребление зараженных продуктов, не подвергшихся термической обработке (молоко и молочные продукты, салаты, винегреты, холодные паштеты, овощи, фрукты, ягоды и т.п.), может вызвать групповые заболевания дизентерией. Возможность возникновения таких вспышек многократно возрастает, если больной дизентерией или бактерионоситель принимает непосредственное участие в приготовлении и выдаче пищи (работники пищевой и молочной промышленности, учреждений общественного питания, детских и юношеских коллективов) и не выполняет гигиенических требований.
- Водный — заражение может произойти при употреблении зараженной фекалиями воды из открытых водоемов (реки, озера, пруды) или при купании в них, а также водопроводов и колодцев.
Симптомы и течение болезни
Инкубационных период при дизентерии составляет от 2-3 дней до 12-24 часов.

Симптомы заболевания дизентерией схожи с симптомами при отравлении: головная боль, напряженность мышц шеи, ломота в суставах, заторможенность, появляется частый стул, который уже через несколько часов приобретает типичный дизентерийный характер — каловых масс мало, но много слизи и прожилок крови.
В начале болезни — обычно повышается температура тела до 3839 °С (в тяжелых случаях до 41 °С), появляются боли в животе. У детей исчезает аппетит, возможна рвота. Возникает частый жидкий стул, (до 10-20 раз в сутки), с примесью слизи и крови, затем он приобретает вид серовато-зеленых слизистых комочков с прожилками крови.
Диагноз — устанавливается на основании клинико -эпидемиологических данных, лабораторных бактериологических исследований — основным из которых является посев кала.
Диагностика и лечение болезни
Продолжительность заболевания дизентерией зависит от характера болезни и степени инфицирования. Различают: легкую форму острую и хроническую, а также дизентерии, среднюю и тяжелую, бактерионосительнство шигелл.
Лечение — как правило, проводится в стационаре инфекционной больницы. Госпитализации подлежат больные со среднетяжелой сопутствующей патологией, дети до 1 года и дошкольных учреждений, работники пищевых объектов и системы водоснабжения, лица, проживающие в общежитиях и др. Необходимо соблюдение диеты в остром периоде болезни и не менее одного месяца в период выздоровления.
Меры профилактики и защиты
Чтобы уберечь себя и других от заражения необходимо:
- Соблюдать правила личной гигиены: тщательно мыть руки с мылом, особенно после посещения туалета, перед и во время приготовления пищи, перед едой, после прихода домой с улицы.
- Воду употреблять только кипяченую (если с момента кипячения прошло не более 6 часов) или питьевую бутилированную из магазина.
- Соблюдать сроки и условия хранения скоропортящихся продуктов, правила приготовления пищи.
- Тщательно мыть фрукты, ягоды и овощи под проточной водой.
- Промывать водой овощи, корнеплоды сразу после того, как принесли из магазина или рынка, перед закладкой в холодильник, пораженные гнилью — тщательно зачищать. Перед употреблением повторно промыть под проточной водой, ошпарить кипятком. Особую трудность для обработки представляет капуста: кочан капусты после зачистки и мытья необходимо разрезать на 4 части, поместить в дуршлаг и опустить в кипящую воду не менее, чем на 2-3 мин.
- Не допускать соприкосновения готовых и сырых продуктов.
- Содержать в чистоте помещение кухни.
- Защищать пищу от насекомых, грызунов и домашних животных, возможных переносчиков инфекции, и вести борьбу с мухами и тараканами.
- Не заниматься самолечением. При первых признаках заболевания обращаться к врачу!
Соблюдая эти простые правила, Вы защитите себя и членов своей семьи от заражения дизентерией.
Профилактика дизентерии

Дизентерия — это инфекционная болезнь общего характера, которую вызывают дизентерийные бактерии. Наиболее часто развитие заболевания провоцируют шигеллы.
Чаще всего диагностируется дизентерия у детей в возрасте от двух до семи лет. Но болезнь может поражать людей из любой возрастной группы.
Симптомы дизентерии в основном проявляются летом. Инфекция распространяется быстро, и если не будут соблюдаться главные правила гигиены, то ребенку может понадобиться лечение дизентерии. Именно поэтому профилактика заболевания состоит, не только в строгом следовании общим гигиеническим нормам, но и в иммунопрофилактике заболевания.
Как передается дизентерия?
Инфекция распространяется от больных острой и хронической формой болезни. Также заражение возможно от бактериовыделителей, которыми являются люди с легким течением недуга. Такие больные ввиду легкости симптомов к врачу не обращаются. Инфекция может передаваться через еду и питье, также ее разносят мухи. Передача возбудителя может произойти и через грязные руки.
Выделяется две формы дизентерии – острая и хроническая. При острой форме заболевания человек может болеть от 3-4 дней до трех месяцев. Если болезнь продолжается дольше, то речь уже идет о хронической форме дизентерии. Длительность инкубационного периода в обоих случаях может колебаться от 18 часов до 5 суток.
Если у больного имеет место среднетяжелое течение болезни, то его признаки выражены более остро. Изначально человек ощущает слабость и недомогание, позже появляются схваткообразные боли в животе. Стул жидкий, с примесями крови и слизи, его частота может доходить до 25 раз в сутки. В первые двое суток развития дизентерии частота стула нарастает. Кроме того у больного повышается температура тела, которая может достигать 39 градусов.
У большинства больных боль в животе продолжается длительное время. Часто отмечается вздутие живота.
При тяжелой форме острой дизентерии все симптомы более выражены: стул очень частый с примесями слизи , крови и гноя; наблюдается рвота, тошнота; температура тела держится длительное время на высоких цифрах. В случае отсутствия адекватного лечения заболевания, оно переходит в хроническую форму.
У детей дизентерия протекает более тяжело. Стул бывает срезу обильным, в нем появляются комочки слизи серо- зеленого цвета. Организм ребенка сильно обезвоживается. Родители должны осознавать и тот факт, что обезвоживание тем опаснее, чем младше ребенок. При тяжелой форме дизентерии у малыша может развиваться сердечно-сосудистая недостаточность, появляются судороги, нарушается сознание.
Лечение дизентерии направлено на уничтожение возбудителей заболевания и у детей младшего возраста проводится в стационаре инфекционного профиля.
Профилактика дизентерии
Для профилактики заболевания очень важно соблюдать все санитарно-гигиенические нормы.
Меры личной профилактики – это, прежде всего, регулярное и тщательное мытье рук. Кроме того, важно вовремя избавляться от мух в помещении и не допускать, чтобы они контактировали с пищевыми продуктами. Родители должны всеми силами обеспечивать защиту ребенка от заражения болезнетворными микроорганизмами. Следует следить не только за тем, чтобы ребенок мыл руки после туалета и прогулок, но и не допускать употребления немытых фруктов, овощей.
В настоящее время заболевания можно избежать путем проведения вакцинации.
Имеющаяся вакцина обеспечивает невосприимчивость к инфекции в течение 1 года.
Вакцина применяется с целью профилактики дизентерии Зонне у взрослых и детей в возрасте от трех лет. Первоочередная вакцинация рекомендуется для :
- детей, посещающих детские учреждения и отъезжающих в оздоровительные лагеря;
- работников инфекционных стационаров и бактериологических лабораторий;
- лиц, занятых в сфере общественного питания и коммунального благоустройства.
Профилактические прививки против дизентерии Зонне предпочтительно проводить перед сезонным подьемом этой инфекции. Прививка проводится однократно.
ПОМНИТЕ, ЧТО НАДЕЖНЕЙ И БЕЗОПАСНЕЙ ИНФЕКЦИЮ ПРЕДУПРЕДИТЬ, ЧЕМ БОРОТЬСЯ С НЕЙ В РАЗГАРЕ И ЕЕ ПЕЧАЛЬНЫМИ ПОСЛЕДСТВИЯМИ!
По вопросам вакцинации Вы можете обращаться к специалистам отделения платных медицинских услуг ГБУЗ АО «ДГП №1» — кабинет 224 , 2 этаж, тел. 48-16-41
Дизентерия у детей: причины заболевания, основные симптомы, лечение и профилактика

Острый бактериальный инфекционный процесс в кишечнике, вызываемый различными видами шигелл. Обычно, у пациентов отмечается повышение температуры, озноб, недомогание, слабость, тошнота, диарея, кровь и слизь в стуле, а также постоянные режущие, тянущие, жгучие боли в животе. Для установки и подтверждения диагноза, врач собирает жалобы, изучает историю болезни, проводит физикальный осмотр и назначает дополнительные лабораторные и инструментальные обследования. Как правило, выполняют бактериологическое исследование, полимеразную цепную реакцию, иммуноферментный анализ крови, реакцию непрямой гемагглютинации, копрограмму и ректороманоскопию. Для лечения назначается диетическое питание, антибактериальная и дезинтоксикационная терапия, иммунокоррекция, и физиотерапия. Кроме того, пациентам могут выписывать прием ферментов и пробиотиков. Обычно, болезнью страдают дети младшего дошкольного возраста.
Причины
Заболевание вызывается антропофильными энтеробактериями рода Shigella. Возбудителями недуга могут быть S.dysenteriae, S.flexneri, S.sonnei, а также S.boydii. Шигеллы могут длительное время сохраняться в почве, воде и на продуктах. Они устойчивы к низким температурам, высушиванию, прямым солнечным лучам, дезинфекторам, но могут погибнуть при кипячении.
Чаще всего, инфекция передается от зараженного человека к здоровому. Также энтеробактерии могут попасть в организм во время употребления зараженных продуктов или воды, при контакте с грязными руками, посудой, бельем, или игрушками. Если дети употребляют продукты, которые не прошли термическую обработку, немытые овощи и фрукты, либо просроченную пищу они рискуют инфицироваться. В основном дети заражаются дизентерией летом или осенью.
Симптомы
Симптоматика заболевания напрямую связанна с видом инфекционного агента, характером течения, степенью тяжести, обширностью поражения и иммунитетом пациента. После инфицирования до появления первых признаков может пройти как несколько часов, так и несколько дней. При остром течении недуга температура тела повышается до фебрильных значений, возникает озноб, выраженное недомогание, тошнота и рвота, а при тяжелом – наблюдаются судороги, синюшный окрас кожи, тахикардия, повышенное давление, а также угнетение сознания. Кишечные расстройства проявляются частой диареей, кровью и слизью в каловых массах, урчанием, болезненными и ложными позывами к опорожнению кишечника. У некоторых пациентов может выпадать слизистая оболочка прямой кишки.
У младенцев дизентерия может осложняться пневмонией или отитом. Как правило, недуг длится 14-21 день, после чего наступает выздоровление.
При осложнениях может развиваться токсический Мегаколон, перфорация, перитонит, гемолитико-уремический синдром, почечная и сердечная недостаточность, а также токсико-инфекционный шок. Если заболевание имеет продолжительное течение, у малышей может образоваться гипотрофия, авитаминоз и анемия.
Диагностика
В диагностике принимают участие специалисты педиатрического и инфекционного профиля. Чтобы установить и подтвердить диагноз врачи собирают жалобы, изучают историю болезни и назначают дополнительные обследования. Как правило, выполняют копрограмму с антибиотикограммой, полимеразную цепную реакцию, иммуноферментный анализ крови, реакцию непрямой гемагглютинации и ректороманоскопию.
Лечение
Терапевтическая тактика включает коррекцию питания и режима дня, прием антибактериальных препаратов, дезинтоксикацию, восстановление иммунной и пищеварительной функций. Симптоматику токсикоза и обезвоживания снимают солевыми растворами или инфузионной терапией. Чтобы купировать болевые ощущения назначают прием спазмолитических препаратов (Дротаверина, Папаверина).
При средней и тяжелой степени болезни после выявления возбудителя осуществляют антибиотикотерапию Ампициллином, Гентамицином, Полимиксином М, Фуразолидоном. Микрофлору и функцию кишечника восстанавливают ферментами (Панкреатином) и пробиотиками.
Профилактика
Чтобы предотвратить распространение недуга больных детей изолируют. Рекомендовано соблюдать санитарно-гигиенические нормы во время приготовления пищи, а также пить только очищенную воду.
Дизентерия у детей: симптомы и лечение
Дизентерия – это острое инфекционное заболевание, поражающее толстый кишечник. Возникает воспалительный процесс, появляются изъязвления слизистой, что проявляется спазмами в животе и диареей с примесью слизи и крови. Дизентерия у детей, особенно раннего возраста, встречается чаще по сравнению со взрослыми. Заболевание может возникнуть в любых условиях, но в основном встречается в условиях тропического жаркого климата и антисанитарии.
Автор: к.мед.н., доцент Возняк Андрей Валериевич
На сегодняшний день распространены такие виды болезни:
- Бактериальная дизентерия – наиболее частая форма. Ее вызывает шигелла – патогенный микроорганизм из рода энтеробактерий. Имеет также название «шигеллез». Встречается повсеместно.
- Амебная дизентерия возникает при попадании в организм амебы – одноклеточного паразита, чаще встречающегося в условиях жаркого климата. Такой формой болезни можно заразиться во время путешествий. Данная форма вызывает у ребенка тяжелое течение болезни.
Дизентерия может возникнуть в любом возрасте, но чаще от нее страдают дети 2-7 лет. Максимальные показатели заболеваемости появляются в летнее время. Малыши в этот период много времени гуляют, купаются в водоемах, играют в песочницах. В грудном возрасте заболевание встречается очень редко. Все потому, что такие дети имеют сильный иммунитет, полученный от матери, а также контакты их в этот период ограничены. Иногда, в 5% случаев, дизентерию можно обнаружить у малышей до 1 года. Причиной заражения может быть употребление некачественной воды или испорченных молочных продуктов. Заболеть есть риск у детей, имеющих отягощенный предшествующий заболеванию фон: рахит, анемию, диатез, гипотрофию, искусственное вскармливание. Течение дизентерии у них может быть крайне тяжелым.
Симптомы дизентерии у детей
При острой форме болезни возникают проявления колита. Признаки дизентерии у детей при этом следующие: частый стул, могут возникать ложные позывы к дефекации. У маленьких детей возникает беспокойство, во время этого они натуживаются.
Шигеллез возникает спустя 1-3 суток после того, когда инфекция попала в организм. Бактериальная дизентерия у детей симптомы имеет следующие:
- жидкие испражнения, в которых со временем появляются слизь и кровь;
- болевые ощущения в животе;
- отсутствие аппетита;
- дефекация происходит с натуживанием, появляется боль в прямой кишке;
- повышение температуры тела, озноб;
- тошнота, рвота;
- признаки обезвоживания организма;
- потеря веса.
Если возникла амебная дизентерия, симптомы у детей после инфицирования могут появиться позже, иногда даже спустя 20 дней. Амебиаз проявляется:
- болью в животе;
- тошнотой, рвотой;
- ознобом, лихорадкой;
- сильной усталостью;
- натуживанием при дефекации, которое сопровождается болью в прямой кишке;
- жидким стулом со слизью, кровью, гноем, с видом как «малиновое желе».
Возможно попадание амеб в другие органы, что усложняет течение заболевания. Симптомы могут сохраняться длительное время (до нескольких недель).
Тяжесть заболевания зависит от того, насколько массивное воспаление, а также от вида возбудителя, возраста малыша и его состояния здоровья, момента инфицирования. Если болезнь возникла в грудном возрасте, чаще возникает ее токсическая форма из-за массивности поражения. У малышей 2-3 лет бывает сильно выраженная интоксикация, она может даже опережать кишечные расстройства. У детей после 4 лет реже бывает обезвоживание организма.
Причины дизентерии у детей
Дизентерия у ребенка возникает при контакте с больным, иногда с человеком со стертым течением заоблевания и даже реконвалесцентом (выздоровевшим). Пациенты заразны уже с первого дня заболевания, так как с калом выделяется большое количество возбудителя.
Заражение может произойти такими путями:
- фекально-оральный;
- водный – при купании в бассейнах, открытых водоемах, употреблении воды;
- контактно-бытовой (через посуду, белье, грязные руки, игрушки);
- пищевой путь – употребление немытых фруктов и овощей, продуктов с недостаточной термической обработкой, просроченных.
Причины дизентерии у детей – попадание в организм их возбудителей – шигелл и амеб.
- Шигеллы – грамотрицательные палочки, анаэробы, которые характеризуются длительной устойчивостью во внешней среде (до 3 месяцев) и пищевых продуктах (до 1 месяца). Мало чувствительны к высушиванию и понижению температуры, но быстро погибают после нагревания. Чувствительны к дезрастворам.
- Амебой поражается толстая кишка. Возбудитель может существовать в вегетативной (активной) форме и неактивной (цистной). Заражение возможно при контакте с инфицированными фекалиями, что случается при нарушении санитарно-гигиенических условий. Пути передачи те же самые, что и при бактериальной форме болезни.
Заболевание может возникать в виде эпидемических вспышек или спорадических случаев. Часто наблюдаются семейные очаги, при этом пик заболеваемости происходит на летне-осенний период. Дизентерия у детей до года встречается в очень редких случаях. Хроническая форма болезни может возникнуть у ослабленных пациентов со сниженным иммунитетом и страдающих сопутствующей патологией.
Лечение дизентерии у детей
Терапия направлена на уничтожение возбудителя, облегчение симптомов и устранение токсинов из кишечника. При данной патологии показан постельный режим, потому что движение может усугубить проявления заболевания.
Первые 2-3 суток рекомендована жидкая диета. Если пострадал младенец, грудное вскармливание не отменяется. Старшим детям нужно давать овощные отвары, жидкие каши, картофельное пюре, кисели, жидкие супы, печеные яблоки. Ни в коем случае нельзя давать трудноперевариваемые продукты и быстро увеличивать объем питания, так могут случаться рецидивы.
Для борьбы с обезвоживанием нужно давать много жидкости. Для этого показаны оральные растворы для регидратации. При наличии лихорадки помогут жаропонижающие средства на основе ибупрофена и парацетамола. Не следует давать антидиарейные препараты по типу лоперамида, так как они могут ухудшить состояние ребенка.
Самолечение при дизентерии категорически противопоказано. Обязательно решение о том, чем лечить дизентерию у детей, должен принять врач, учитывая многие факторы: бактериологические исследования, возраст пациента, тяжесть заболевания. Могут назначаться такие группы препаратов:
- антибиотики;
- оральные регидратационные средства;
- ферментные препараты для нормализации желудочной секреции;
- дезинтоксикационная терапия;
- вспомогательные средства для нормализации микрофлоры кишечника – про- и пребиотики.
При легкой форме дизентерии выздоровление возможно через 2-3 недели. Но чтобы полноценно восстановится, организму требуется несколько месяцев. Обязательно нужно соблюдать диету, так как существует высокий риск рецидивов.
Выписка из стационара проводится спустя 3 дня с момента абсолютного выздоровления (нормализация температуры тела, стула). Обязательно нужно получить отрицательное бактериальное исследование, которое проводят через 2 дня после окончания приема антибактериальных препаратов. Диспансерное наблюдение за переболевшими детьми – 3-6 месяцев.
Профилактика дизентерии
Обязательно с раннего возраста стоит научить ребенка следить за личной гигиеной. Дизентерия у детей боится воды и мыла, поэтому если тщательно мыть руки после прогулок, посещения туалета, перед употреблением пищи, можно избежать риска развития болезни.
При путешествиях, особенно в другие страны, нужно обратить внимание на такие моменты:
- Употреблять бутилированную воду, избегать местной водопроводной. Если нет возможности купить воду, в крайнем случае ее следует прокипятить.
- При чистке зубов малышу не пользоваться сырой водой.
- Избегать использования полотенец в общественных местах.
- Не покупать напитки и пищу у уличных торговцев.
- Избегать употребления немытых фруктов, овощей.
Хотя дизентерия у ребенка – распространенная болезнь, которая может полностью излечиваться, она может быть опасной, особенно для детей раннего возраста. Поэтому, при возникновении любых признаков, которые могут указывать на данную патологию, следует сразу же обратиться к врачу.
- Инфекционные болезни – Евгения Шувалова. Серия: Учебник для медицинских вузов. Издательство Медицина, 2015 г. 696 страниц.
- Пищевые инфекции. Дизентерия, сальмонеллез, лямблиоз, аскаридоз. Автор Валентина Шабанова. Издательство Слог. 2014 год. 160 страниц.
- Здоровье вашего ребенка. Книга для разумных родителей. Авторы: Староверов Юрий Иванович, Шабалов Николай Павлович. Издательство Питер. 2014 год, 352 страницы.
- Все о детских болезнях. Книга умных родителей. Авторы: Е. Федорова. Книжкин Дом, 2012 год. 791 страница.
Лабораторная диагностика дизентерии

Различают 4 вида шигелл: Флекснера, Зонне, Бойда, дизентерии.
Важная особенность шигелл в том, что они способны менять чувствительность к лекарственным препаратам. Если какое-либо антибактериальное средство достаточно часто используется в отдельном регионе (например, при выращивании птицы), то возбудитель может оказаться нечувствительны к данному препарату. Это значительно затрудняет терапию.
Лекарственная устойчивость возбудителей, их способность выживать во внешней среде с некоторых пор снова приводят к массовым вспышкам дизентерии и даже крупным эпидемиям, во время которых летальный исход составляет до 5 % от заболевших.
Главный фактор в патогенезе дизентерии — это выделение токсинов, обуславливающих основные клинические проявления. Дизентерийные токсины действуют местно в просвете кишечника, всасываясь в кровь, воздействуют на стенки сосудов, центральную нервную систему, печень, органы кровообращения.
Выделяют несколько форм и вариантов заболевания:
• Острая дизентерия в колитическом, гастроэнтеритическом, гастроэнтероколитическом вариантах с легким, средне-тяжелым и тяжелым течением;
• Возможно стертое и затяжное течение заболевания;
• Хроническая дизентерия в рецидивирующей или непрерывной форме;
Симптомы дизентерии и осложнения
Инкубационный период длится обычно 3 дня, но, в зависимости от возбудителя, состояния организма и инфицирующей дозы (количество проникших клеток) может затягиваться до 7 дней или сокращаться до суток.

При колитическом варианте болезнь развивается остро с повышением температуры, снижением аппетита, тошнотой, интенсивной режущей болью в животе. Сначала боль разливается по всему животу, потом концентрируется внизу и в правой подвздошной области. Течение болезни сопровождается диареей — 10 и более раз за сутки. При этом кал быстро теряет нормальную консистенцию, в нём появляются примеси в виде крови, слизи, гноя, а позывам к дефекации сопутствует мучительная боль. Столь острые клинические симптомы постепенно исчезают через неделю-полторы, а язвенные поражения слизистой — примерно через месяц.
Гастроэнтеритический вариант характеризуется тошнотой, рвотой, диареей с обильным жидким стулом. Боль в этом случае локализуется в области пупка, эпигастральной области.
Гастроэнтероколитический вариант характеризуется сочетанием колитического и гастрокэнтеритического синдромов
Частым явлением стала стёртая дизентерия. При такой форме больной испытывает легкое недомогание, умеренную болезненность в животе без определённой локализации, у него жидкий или кашицеобразный стул с обычным интервалом — 1—2 раза за сутки. Дизентерия, продолжающаяся более трех месяцев, диагностируется как хроническая. Чтобы избежать более тяжёлых последствий и перерастания болезни в хроническую форму, необходимо при подозрительных симптомах обязательно сдать анализы.
Осложнения при дизентерии:
• выпадение прямой кишки.
Осложнения возникают при запоздалом обращении к врачам, тяжёлых случаях, неправильно выбранной терапии, как следствие низкого качества диагностики или квалификации врача. Чтобы тяжёлых последствий избежать, нужно обращаться к врачу при первых симптомах и проходить лабораторные исследования в надёжных, и современных лабораториях.
Источники инфекции, механизмы передачи
Источник инфекции — человек, больной различными формами дизентерии, в том числе и бессимптомными. Заражение реализуется контактно-бытовым, водным и пищевым путями. Болеют люди всех возрастных групп, наиболее подвержены лица с ослабленным иммунитетом и дети дошкольного возраста. Заболевшие дизентерией опасны для окружающих почти сразу после заражения и в течение всего периода реконвалесценции (выздоровления). Если же болезнь приобретает хроническую форму, то выделение возбудителя происходит месяцами. Нужно отметить, что у людей восприимчивость к болезни разная.
Исследуемый материал для диагностики дизентерии
Возбудитель при дизентерии выделяют из испражнений.
Возможно исследование крови для определения антител к шигеллам (ответная реакция организма на встречу с возбудителем заболевания).
Методы лабораторной диагностики дизентерии
Копрограмма — это анализ кала: его состава, свойств, примесей. При шигеллезе в кале обнаруживаются включения слизи, скопления лейкоцитов более 20-30 в поле зрения, эритроциты и эпителиальные клетки.
Общий анализ крови
При тяжёлой форме шигеллеза отмечают следующие изменения:
• лейкоцитоз с нейтрофильным сдвигом формулы влево;
• токсическую зернистость нейтрофилов;
Бактериологический посев
Это ведущий специфический метод диагностики дизентерии, который заключается в проведении посева кала на специальные питательные среды для выделения патогенных бактерий. Бактериальный посев используют как подтверждающий анализ, потому что его результаты известны только через 2-5 дней. Однако он чрезвычайно важен для точной постановки диагноза и определения чувствительности к антибактериальным препаратам. По результатам исследования врач корректирует проводимое лечение
Серологическое исследование
Задачей серологической диагностики является определить специфические антитела в крови к основным видам шигелл. Для анализа используют реакцию непрямой гемагглютинации — РНГА. В разведённую сыворотку крови в лаборатории добавляют эритроциты с антигенами шигелл разных видов. Через сутки результат готов: если в пробах есть специфические иммунные антитела к шигеллам, то образуются агглютинины. Антитела при дизентерии появляются в конце первой недели болезни и достигают максимума на 21-25 день, затем титр антител уменьшается. Поэтому целесообразно использовать метод парных сывороток, то есть исследовать две пробы крови, взятые с интервалом 10-14 дней. Диагностическое значение имеет нарастание титра антител в четыре и более раз.
Полимеразная цепная реакция (ПЦР) – заключается в определении фрагментов ДНК шигелл в кале. Это быстрый и надежный метод исследования.
Ректороманоскопия
Это инструментальный метод диагностики, который проводят с помощью ректоскопа, вводимого в анальный проход больного. С помощью окуляра врач оценивает состояние слизистой, определяет изменения, характерные для дизентерии.
Профилактика и лечение дизентерии
Лечение дизентерии может проводиться дома, либо в стационаре (в случае средней или тяжелой форма болезни). Госпитализация также необходима и людям с тяжёлыми сопутствующими, хроническими патологиями.
Лечение заключается в приёме антибиотиков, специфических дизентерийных бактериофагов, строгом постельном режиме и специальной диете (стол № 4) с нежирными бульонами, куриным мясом, нежирной рыбой, киселями, кашами, зелёным чаем, отваром шиповника.
Профилактикой заболевания является строгое соблюдение личной гигиены, медицинский осмотр людей, работающих в местах общественного питания, постоянный контроль водных источников, общественных водоёмов, бассейнов, предприятий питания и т. д.
Как сдать анализ на дизентерию в АО «СЗЦДМ»
Только раннее выявление заражения шигеллами гарантирует минимальный риск здоровью и скорое выздоровление. Потому при первых признаках недомогания и в качестве профилактики необходимо пройти лабораторные исследования на предмет заражения возбудителем шигеллёза.
Сделать это легко в подразделениях АО «СЗЦДМ». По интерактивной карте вы сможете определить ближайший к вам пункт исследований и выбрать удобное время. На сайте или через колл-центр можно записаться на приём к врачу.
Во всех наших лабораториях работают квалифицированные сотрудники, используются современные методики исследований и гарантирована полная безопасность вашему здоровью и сохранность — личным данным.
Будьте здоровы!
Лаборатория АО «СЗЦДМ» предлагает услуги, обеспечивающие комплексное и преемственное лабораторное обследование пациента
Диагностика В медицинских центрах АО «СЗЦДМ» проводят качественные диагностические исследования всего организма
Лечение Наши медицинские центры ориентированы на обслуживание пациентов в амбулаторном режиме и объединены единым подходом к обследованию и лечению пациентов.
Реабилитация Реабилитация — это действия, направленные на всестороннюю помощь больному человеку или инвалиду для достижения им максимально возможной полноценности, в том числе и социальной или экономической.
Профосмотры АО «СЗЦДМ» проводит профилактические осмотры работников, которые включают в себя — комплексы лечебных и профилактических мероприятий, проводимых для выявления отклонений в состоянии здоровья, профилактики развития и распространения заболеваний.
Дизентерия у детей
Дизентерия у детей – острая бактериальная кишечная инфекция, возбудителем которой являются различные виды шигелл. Дизентерия у детей проявляется интоксикационным (лихорадкой, недомоганием, слабостью, тошнотой) и колитическим синдромами (диареей с примесью крови и слизи, болями в животе, тенезмами). Дизентерию у детей подтверждают данные бактериологического исследования, ПЦР, ИФА, РНГА, копрограммы и ректороманоскопии. В лечении дизентерии у детей применяют диету, антибактериальную и дезинтоксикационную терапию, иммунокоррекцию, ферменты, пробиотики, физиотерапию.

- Причины дизентерии у детей
- Симптомы дизентерии у детей
- Диагностика дизентерии у детей
- Лечение дизентерии у детей
- Прогноз и профилактика дизентерии у детей
- Цены на лечение
Общие сведения
Дизентерия (шигеллез) – инфекционное заболевание, характеризующееся поражением слизистой оболочки толстого кишечника (преимущественно, его нижнего отдела), диареей и общим интоксикационным синдромом. Дизентерия занимает одно из ведущих мест среди острых кишечных инфекций, причем до 60-70% переболевших ею составляют дети. Более высокая восприимчивость к дизентерии наблюдается у детей от 2 до 7 лет, значительно реже заболевание встречается в первый год жизни ребенка. Проблемы снижения заболеваемости дизентерией среди детей, совершенствования методов диагностики, улучшения результатов лечения и реабилитации весьма актуальны для педиатрии и инфекциологии.

Причины дизентерии у детей
Дизентерию у детей вызывает большая группа антропофильных энтеробактерий рода Shigella, включающая 4 вида возбудителей (S. dysenteriae, S.flexneri, S.sonnei, S.boydii) и около 50 серотипов. Шигеллы — морфологически схожие между собой грамотрицательные, не образующие спор палочки, являющиеся факультативными анаэробами и различающиеся по биохимическим и серологическим свойствам. Возбудители дизентерии у детей достаточно устойчивы во внешней среде: долго сохраняются в воде и почве (до 3 мес.), продуктах питания (15-30 дней), хорошо переносят низкие температуры и высушивание; но чувствительны к нагреванию (погибают через 30 мин. — при 60°C, мгновенно – при 100°C), прямому солнечному свету и дезинфицирующим препаратам.
Источником заражения служит больной человек, часто с легким и стертым течением дизентерии, реже — реконвалесцент. Дети с дизентерией заразны для окружающих с первого дня болезни, так как выделяют с фекалиями большое количество шигелл.
Механизм заражения дизентерией – фекально-оральный; передача инфекции у детей осуществляется пищевым, водным (через водопровод, при купании в водоемах и бассейнах) и контактно-бытовым (через грязные руки, посуду, белье, игрушки) путями. Риск инфицирования дизентерией у детей возрастает при употреблении продуктов, не подвергнутых предварительной термической обработке, с истекшим сроком годности, немытых фруктов и овощей.
Дизентерия у детей возникает в виде спорадических случаев или эпидемических вспышек, развитию которых способствуют аварии водопровода и канализации, неблагоприятные метеоусловия (циклоны, наводнения, паводки). Типично возникновение семейных эпидемических очагов дизентерии: от больных членов семьи заражаются 40% детей. Пик заболеваемости дизентерией среди детей приходится на летне-осенний период. Формирование хронической дизентерии наблюдается у детей со сниженным иммунитетом, сопутствующими заболеваниями, при присоединении интеркуррентных инфекций (ОРВИ и др.).
Симптомы дизентерии у детей
Клинические особенности дизентерии зависят от вида возбудителя (Зонне, Флекснера и т.д.), характера течения (острый или хронический), выраженности проявлений (легкая, средней тяжести или тяжелая формы), обширности поражения ЖКТ (гастроэнтерит, колит, гастроэнтероколит), преморбидного фона и иммунитета ребенка.
Инкубационный период при дизентерии у детей продолжается от нескольких часов до недели (обычно 2-3 суток) и переходит в характерное острое начало заболевания. Уже в первые сутки инфекция проявляется выраженным недомоганием, лихорадкой (от 37,5 до 40°С), тошнотой, рвотой (однократной или повторной); в тяжелых случаях – угнетением сознания, судорогами, цианозом, тахикардией и гипотонией.
Кишечная дисфункция при дизентерии у детей характеризуется учащенным (от 5-8 до 10-25 раз в сутки) жидким стулом с примесью мутной слизи, зелени и прожилок крови; по характеру сначала обильным и каловым, на 2-3 сутки заболевания – очень скудным («ректальный плевок»). Отмечается урчание по ходу толстой кишки, болезненные, часто ложные, позывы на дефекацию (тенезмы). Выраженное и частое натуживание (особенно у детей младшего возраста) может привести к податливости или зиянию ануса, реже — выпадению слизистой оболочки прямой кишки.
У детей первого года жизни дизентерия наблюдается, как правило, при рахите, анемии, диатезе, искусственном вскармливании. Симптомы развиваются постепенно, стул остается каловым с избытком слизи и зелени, редко с примесью крови; специфический токсикоз может быть не резко выражен, тяжесть состояния обусловлена нарушением гемодинамики и водно-минерального обмена. У грудных детей, больных дизентерией, имеется склонность к развитию вторичной бактериальной инфекции (пневмонии, отитов).
Дизентерия Зонне у детей чаще имеет субклиническое, стертое течение с гастроэнтеритическим поражением ЖКТ, без деструктивных изменений слизистой. Для дизентерии Флекснера у детей характерно более интенсивное поражение кишечника и более тяжелое течение.
При неосложненном течении дизентерии у детей клиническое выздоровление наступает обычно через 2–3 недели, но полное морфо-функциональное восстановление ЖКТ длится до 2 -3 месяцев и более; имеется риск обострения при нарушении диеты.
Тяжелые случаи дизентерии у детей могут осложниться формированием токсического мегаколона, перфорацией толстой кишки, перитонитом; в редких случаях — развитием гемолитико-уремического синдрома, почечной и сердечной недостаточности, токсико-инфекционного шока, летального исхода.
Хроническая дизентерия у детей нередко протекает при удовлетворительном общем состоянии, слабой интоксикации, наличии жидкого или полужидкого стула калового характера, иногда со слизью и прожилками крови. Длительное течение дизентерии ослабляет детей, приводит к гипотрофии, авитаминозу, анемии.
Диагностика дизентерии у детей
Дети с подозрением на дизентерию должны быть изолированы, осмотрены педиатром и инфекционистом. Диагноз дизентерии у детей ставят на основании эпидемиологического анамнеза, клинической картины, лабораторных данных.
Возбудителя кишечной инфекции идентифицируют путем бактериологического исследования кала и рвотных масс с обязательным определением чувствительности выделенной микрофлоры к антибиотикам. В сомнительных случаях для выявления шигелл и специфических антигенов в фекалиях и крови используют ПЦР и серологические методы (РНГА, РКА, ИФА). Результаты копрограммы и ректороманоскопии при диагностике дизентерии у детей имеют вспомогательное значение.
Дизентерию у детей необходимо дифференцировать от инфекционных колитов, энтероколитов и гастроэнтеритов другой этиологии: сальмонеллеза, энтеропатогенного эшерихиоза, иерсиниоза, амебиаза, вирусной диареи, а также экссудативной энтеропатии, неспецифических язвенных колитов и болезни Крона.
Лечение дизентерии у детей
Лечение дизентерии у детей определяется формой и тяжестью заболевания, возрастом и общим состоянием пациента и в зависимости от этого может проводиться в стационаре или амбулаторно. Комплексное лечение детей с дизентерией включает режим, лечебное питание, антимикробную и дезинтоксикационную терапию, иммунокоррекцию, восстановление функции пищеварительной системы.
В острый период дизентерии дети должны соблюдать постельный режим. Диета назначается согласно возрасту ребенка: в первые 1-3 суток питание дробное с уменьшением суточного объема пищи и увеличением кратности приема. У детей до года, находящихся на искусственном вскармливании вводят кисломолочные продукты (кефир, биолакт). Детям старше года показана механически и химически щадящая пища (рисовая и манная каши, овощной отвар, овощное пюре, мясной фарш, кисели, слизистые супы, творог).
При токсикозе и обезвоживании легкой степени ребенку дают пить солевые растворы; в тяжелых случаях показана инфузионная терапия. Болевой синдром купируют спазмолитическими средствами (дротаверин, папаверин).
При тяжелых и среднетяжелых формах дизентерии у детей применяют антибиотики (ампициллин, гентамицин, полимиксин М, налидиксовая к-та), нитрофураны (фуразолидон) с учетом чувствительности циркулирующих в данной местности штаммов. Целесообразно назначение поливалентного дизентерийного бактериофага.
Антидиарейные средства при дизентерии у детей грудного и раннего возраста не используют. Для восстановления функции и биоценоза кишечника при дизентерии у детей показаны ферменты (пенкреатин), пробиотики и пребиотики. В реабилитационном периоде детям, перенесшим дизентерию, рекомендованы препараты, повышающие иммунитет, витамины А, С, В, фитосборы, физио- и санаторно-курортное лечение.
Затяжные и хронические формы дизентерии у детей лечатся как острый процесс. Дизентерия у детей считается излеченной после нормализации клинической картины и отрицательного результата контрольного бактериологического исследования, но еще в течение 1 месяца необходимо наблюдение со стороны детского врача-инфекциониста.
Прогноз и профилактика дизентерии у детей
В случае проведения полноценной терапии дизентерия у детей полностью излечивается. При тяжелом течении дизентерии у детей и высоком уровне токсемии высока вероятность осложнений.
Предупредить дизентерию у детей можно при обязательном соблюдении правил личной гигиены; строгом контроле источников водоснабжения, норм хранения, приготовления и реализации пищевых продуктов; выявлении больных в дошкольных и школьных учреждениях, среди работников молочных кухонь, предприятий общественного питания; проведении карантинных и санитарных мероприятий.
